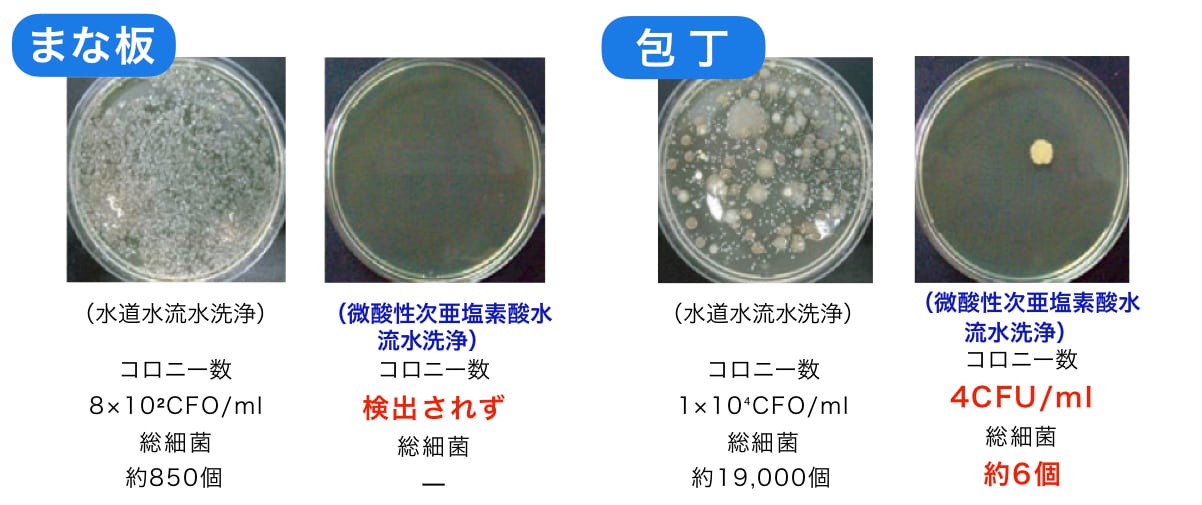

50ppm 微酸性次亜塩素酸水(微酸性電解水)除菌ジアカインド 250mlスプレー2本セット
¥1,485税込
¥1,980 25%OFF
なら 手数料無料で 月々¥490から
※この商品は、最短で8月25日(月)にお届けします(お届け先によって、最短到着日に数日追加される場合があります)。
別途送料がかかります。送料を確認する
電気分解によって生成された微酸性次亜塩素酸水です。希釈せずにすぐに使える濃度50ppmです。pH5〜6.5と微酸性で人体に優しい成分なので肌荒れの心配がありません。保育園やお年寄りが集まるグループホームではオールシーズン除菌に利用されています。また給食室では食中毒対策に使用されています。 一般社団法人日本微酸性電解水協会に認可された安心できる生成方法で受注製造でお届けしています。 大切な人にいつも健康でいてほしいと思う方にオススメです。 【商品仕様】 成分:微酸性次亜塩素酸水 原料:希塩酸、水 使用期限:製造日より2ヶ月(製造日の記載あり) 製品有効塩素濃度50ppm 詳しくは使用説明書をご覧下さい。
微酸性次亜塩素酸水「除菌ジアカインド」の製造方法
次亜塩素酸水には様々な製造方法がありますが、弊社で製造している微酸性次亜塩素酸水「除菌ジアカインド」は希塩酸を電気分解して得られる製造方法です。
無隔膜電解槽で次亜塩素酸を生成し、水道水で調整しながら作っています。
微酸性次亜塩素酸水「除菌ジアカインド」は、一般社団法人日本微酸性電解水協会にも認可された安心できる製造方法で、「キレイの創造」を経営理念に掲げている有限会社クリンシアが製造及び販売をしています。

製造するたびに、有効塩素濃度、液性(pH値)を測定し、製造直後の有効塩素濃度は約40〜50ppm、液性(pH値)はpH5〜6.5になるよう、お客様に安心・安全にご使用いただけるように調整しています。
インフルエンザ、ノロウイルス、食中毒、口蹄疫やその他人間に害を及ぼす可能性のある菌やウイルスの被害は予防をしていてもなかなかゼロになりません。
毎年集団感染事例などが報告されているのが現状です。
「キレイの創造」を事業理念として掲げている我が社は、皆さんにきれいで安心・安全な空間や社会生活を提供できるようにするのが使命だと考え、微酸性次亜塩素酸水「除菌ジアカインド」を広める活動を行っています。
※【除菌ジアカインド】は商標申請中の商品です。(2020年6月)
微酸性次亜塩素酸水「除菌ジアカインド」の成分と原料
「除菌ジアカインド」の成分は微酸性次亜塩素酸水であり、原料は希塩酸(希釈した塩酸)と水です。
※電気分解によって生成する方法ではなく、次亜塩素酸ナトリウムと酸を混合して生成する「pH調整次亜塩素酸ナトリウム水溶液」は食品添加物として認められていません。
有効塩素濃度「40〜50ppm」
有効塩素濃度「ppm」とは、液体の微量な濃度を示す際に用いられる「100万分の1」という割合を示す言葉です。
「ppm」は%(パーセント)と同じように使います。
「ppm」は100万分の1を表すので、0.1%で1,000ppm、0.1%で100ppm、0.001%で10ppm、0.0001%で1ppmとなります。
この数値が高いほど良いということではなく、高い濃度のものは希釈しないと安全に使用することはできません。
また、水で希釈しても思うようにpH値は下がりにくかったり、水や酸で調整すると除菌力が弱くなってしまうデメリットもあります。
そのため、微酸性次亜塩素酸水「除菌ジアカインド」は希釈せずに効果的な使用ができるように、製造時の有効塩素濃度が40〜50ppmになるように製造しています。
微酸性次亜塩素酸水「除菌ジアカインド」は一般細菌、食中毒菌、病原菌、真菌、ウイルスに有効であり、芽胞菌は45ppm以上で有効です。

(日本電解水協会 微酸性電解水使用マニュアルより引用)
微酸性次亜塩素酸水「除菌ジアカインド」は幅広い種類の微生物に短時間(数秒~数十秒)で効果を示すことが確認されています。
細菌芽胞やカビの分生胞子などの一部には抵抗性の強い物があり、他の微生物より長い時間(5~60分)を要する物があります。
人や環境に優しい「pH5〜6.5」の微酸性
微酸性次亜塩素酸水「除菌ジアカインド」の液性(pH値)はpH5〜6.5になるように生成しています。

pH5〜6.5は微酸性なので手肌に優しく、人やペットにも安心であり、水道水と同じように使うことができます。
また、微酸性の状態は次亜塩素酸が安定して水の中で存在でき、強い除菌力が持続されるということで化学的にも安定しています。
また、微酸性は環境にも優しいというメリットがあります。
通常、塩素系殺菌剤を使うと発ガン性があると言われているクロロホルムが作られやすくなると言われています。
アルカリ性になると一気にクロロホルムは作られやすくなりますが、酸性〜中性ではほとんど作られません。
微酸性次亜塩素酸水「除菌ジアカインド」は微酸性であることと、除菌力の高さを生かして使用する濃度を低く設定していることで、クロロホルムは生成されません。
塩素はその水溶液のpHによって形を変えることが知られています。
酸性側の「次亜塩素酸」とアルカリ性側の「次亜塩素酸イオン」とでは、除菌力に大きな相違があり、次亜塩素酸イオンは次亜塩素酸の約1/100程度の除菌力しかないと言われています。
従って、迅速な除菌を必要な場合にはpHが低い方が好ましいと言えます。
ただし、pHが低くなればなるほど酸性になりますので、金属の腐食を促進してしまう恐れもあります。
「除菌ジアカインド」は最も効果の良いpH域5.0〜6.5で調整をし、低濃度で確実な除菌力が得られます。
製造年月日、使用期限について
微酸性次亜塩素酸水「除菌ジアカインド」は製造された時点から、徐々に効果が下がっていきます。
なので、使用期限は未開封で製造年月日より半年、開封後は約2ヶ月とし、製造年月日と使用期限を商品1つ1つに明記しています。
開封後は使用期限を約2ヶ月としていますが、2ヶ月経過後にピタッと効果がなくなる訳ではありません。
一般的に有効塩素濃度は1日約1ppmずつ下がっていくと言われていますので、開封後は早めのご使用をオススメします。
※スプレータイプは開封、未開封関係なく使用期限は約2ヶ月とさせていただいています。
微酸性次亜塩素酸水「除菌ジアカインド」5つの特徴
①除菌効果に即効性アリ!
除菌ジアカインドは次亜塩素酸が98%も含まれているため、細菌、カビ菌、ウイルス、芽胞菌などにすばやく効果を発揮します。
②成分が残留しないため安心!
除菌ジアカインドは分解されやすいため、残留性が少ないです。
有機物に反応すると有効成分は消失し、塩などの残留物も残らないため、色々な用途に使えます。
たっぷり使用することで、常に新しい微酸性次亜塩素酸水が殺菌したいところに反応するようにすれば、除菌効果を下げることなく対処できるようになります。
ベタつきもなく物に対する悪影響もありません。
③調理器具や食品の除菌洗浄にも使用可能!
除菌ジアカインドは味や臭いがほとんどないので調理器具や生野菜や果物、お肉、魚介類などの食品の品質を落とすことなく洗浄が可能です。
【厨房除菌テスト結果】
調理場のまな板・包丁を水道水及び微酸性次亜塩素酸水で洗浄し、菌数を算定したものです。
器具の表面を滅菌綿棒で拭き取り、滅菌水へ投入混振後、液中の1mlを採取し培地へ接種、培養したものがこちらです。


(某食品加工工場)
※食品は洗浄後に流水で洗浄してください。
④人と環境に優しい!
微酸性次亜塩素酸水は食品添加物指定のために実施された安全性試験で「人の健康を害しない」と評価されています。
万が一誤飲したり目に入ったとしても特に異常は起こりません。
有機物に触れると水に戻るため環境に影響を与えません。
⑤使用目的を選びません!
除菌したいところ、消臭したいところに直接スプレーしてご使用ください。
水に濡れても大丈夫な場所やモノであれば、直接スプレーし、しばらく時間を置いてから拭き取った方が効果的です。
また、水に濡れてはいけない場所やモノの除菌に使用する場合は、クロスに液を含ませたもので拭き取ると効果的な除菌になります。
細菌やウイルスを除菌、不活化させるだけでなく、菌が原因となる嫌な臭いも同時に取り除きます。
微酸性次亜塩素酸水と他の除菌剤との比較

(日本電解水協会 微酸性電解水使用マニュアルより引用)
次亜塩素酸が少ないと即効性がなかったり、取り扱いに注意が必要だったりとデメリットがありますが、微酸性次亜塩素酸水(微酸性電解水)は次亜塩素酸を98%も含有しているので、即効性と安全性が高いというメリットがあります。
各種消毒・除菌剤の安全性と除菌力比較

(日本電解水協会 微酸性電解水使用マニュアルより引用)
世の中には様々な消毒液や除菌液などありますが、どんな菌やウイルスに効果があるのかはそれぞれ違ってきます。
また、濃度によっても効果にばらつきがあったり取り扱いに注意が必要な点もあります。
健康を守るための除菌なので、やはり安全に健康を守れた方が大切な人と安心できる生活を送れるのではないでしょうか。
微酸性次亜塩素酸水「除菌ジアカインド」が使える場所
・保育園、幼稚園
・学校
・病院
・介護施設
・飲食店
・食品加工工場
・人の出入りが多い場所
・農畜産業
・ホテル、旅館
・遊技場
など、微酸性次亜塩素酸水(微酸性電解水)「除菌ジアカインド」は、除菌だけでなく消臭効果も高いので、臭いが気になる使用後のトイレや介護中のアンモニア臭、ゴミ箱の臭いの消臭にも使用可能です。
アンモニア臭に悩まされている医療や介護関係で働かれている方々にも、職場環境が快適になったと喜ばれています。
「除菌ジアカインド」の使用方法
微酸性次亜塩素酸水「除菌ジアカインド」は有機物に触れると分解されやすいので、清潔な状態にした後にたっぷりと使用することをオススメします。
【調理器具の除菌】
中性洗剤で洗浄し汚れを落とした後、まな板や包丁などにまんべんなくスプレーし、5分程度そのままにして除菌します。
そのあと、水ですすぎ洗いしてください。
食中毒が発生しやすい時期こそ、食中毒対策として「除菌ジアカインド」で除菌しましょう。
【洗いにくい布製品の除菌】
直接スプレー噴霧し、よく乾かしてください。
ソファーやカーテン、カーペットなど臭いが気になるけど洗いにくい布製品に「除菌ジアカインド」をスプレーすると臭いの原因である雑菌の繁殖を抑え、清潔を保てます。
子どもや赤ちゃんのそばにも洗いにくい布製品がいっぱいあります。
肌に直接触れるカーペットや布団、口にいれてしまうおもちゃ、汗をいっぱいかいた帽子やカバンなどに「除菌ジアカインド」をたっぷりスプレーして、雑菌も臭いもしっかり除菌消臭しましょう。
【トイレの除菌】
「除菌ジアカインド」ですすいだタオルで拭くか、直接スプレー噴霧した後清潔なタオルで拭き取ってください。
トイレは雑菌が繁殖しやすい場所です。
「除菌ジアカインド」で掃除すれば除菌も完璧、清潔です。
【トイレの消臭】
スプレー噴霧した後、乾かしてください。
「除菌ジアカインド」はアンモニアを無臭物質に変える効果があります。
目立った汚れがないのに尿のニオイが気になる時は、ぜひ使用してみてください。
【住宅、施設の除菌】
床、壁、手すり、ドアノブ、スイッチ、テーブルなどに直接スプレー噴霧し、清潔なタオルで拭き取ってください。
「除菌ジアカインド」を含ませたタオルやモップで拭き取るのも可能です。
拭き取りに使用したタオルやモップも除菌できているので、独特な生乾きの臭いもありません。
【浴室・浴槽・足拭きマットの除菌】
浴室や浴槽を中性洗剤で洗い、流水で洗い流したら「除菌ジアカインド」をスプレーしてください。
浴室が広い場合は「蓄圧式スプレー」や「ジョウロ」などを用いて効率よく除菌をしましょう。
足拭きマットは雑菌の温床です。
使用後などにこまめにスプレーするのも効果的です。
【ベビー用品の衛生管理】
「除菌ジアカインド」ですすいだタオルで拭くか、スプレー噴霧した後、清潔なタオルで拭き取ってください。
「除菌ジアカインド」は有機物に触れると分解されやすい性質を持っているので、安全無害です。
【ペットのニオイ、衛生管理】
散歩後の足や体の汚れを落とし、体の除菌・消臭としてスプレー噴霧してください。
安全無害なので、大切なペットの除菌・消臭としてご使用いただけます。
ペットが粗相した際も、汚れを拭き取ったあとスプレー噴霧することで消臭に効果的です。
【衣類や靴の除菌・消臭】
直接スプレー噴霧し、よく乾かしてください。
一日使用した服や靴、持ち物に「除菌ジアカインド」をスプレーすると、除菌・消臭され翌朝スッキリと使用できます。
靴のニオイのもとは細菌によるものです。
足の汚れや垢を栄養にどんどん繁殖してニオイの成分を出していきます。
「除菌ジアカインド」をスプレー噴霧して除菌すると靴の嫌な臭いも消し去ります。
【生ゴミのニオイ対策】
直接スプレー噴霧します。
生ゴミのニオイは食品そのもののニオイの他、雑菌が大繁殖しているので強烈なニオイを発しています。
「除菌ジアカインド」をスプレーするとすばやく除菌され、結果的に消臭される仕組みです。
ニオイが酷い場合やゴミの量が多い時にはたっぷりスプレーしてください。
【タバコのニオイの消臭】
喫煙後のエチケットとして「除菌ジアカインド」を衣服にシュッと吹きかければ、速攻でタバコのニオイを消してくれます。
使用後の灰皿の除菌消臭にもお使い頂けます。
【拭き掃除】
拭き掃除の仕上げに「除菌ジアカインド」をスプレー噴霧し、乾いた清潔なタオルで拭き取れば除菌消臭ができて衛生的です。
濡れて水分を含んだ雑巾やタオルは雑菌が繁殖しやすく、だんだんと臭ってくるのは雑菌の仕業です。
雑菌を含んだ雑巾やタオルで水拭きしても、雑菌が塗り拡げられてしまうことになります。
拭き掃除で使い終わった雑巾やタオルは、汚れを洗い落とし、「除菌ジアカインド」にしばらくつけ置きすることで除菌消臭が可能です。
つけ置き後は、すすぎ洗いをし、十分に乾燥させてください。
微酸性次亜塩素酸水「除菌ジアカインド」のよくあるご質問
Q1.使用期限が製造日より2ヶ月とありますが、過ぎると使えなくなるんですか?
A.経時変化などによって有効成分が失活する性質がありますので、開封後はなるべく早めにご使用ください。
また、2ヶ月経過後ピタッと効果がなくなる訳ではありません。
一般的に有効塩素濃度は1日約1ppmずつ下がっていくと言われているため、早めのご使用をオススメしています。
Q2.保管はどのようにすればいいですか?
A.日光(紫外線)が当たらない涼しい場所に保管して下さい。
Q3.容器・スプレーボトルはどのようなものが良いですか?
A.日光(紫外線)に当たると効果が下がるため、遮光性のある容器・スプレーボトルがオススメです。
新品のスプレートリガーは可塑剤などが使用されている場合があるので十分に洗ってからご使用ください。
蛍光灯の光は問題ありません。
Q4.キャップ(フタ)の無い容器でも大丈夫ですか?
A.空気に触れる面積が広いほど塩素が抜けていくため、キャップ(フタ)がある容器をオススメします。
Q5.使用済みのペットボトルを洗って、スプレーのみを取り付けても良いですか?
A.問題ありませんが、透明な容器の場合は日光に当てないように使用してください。
Q6.洗剤や園芸資材用の容器を洗って使用しても良いですか?
A.十分に洗えば問題ありません。
Q7.ON-OFFのついていない容器でも大丈夫ですか?
A.問題ありません。
Q8.スプレーしたあと拭き取らなくても大丈夫ですか?
A.乾く量のスプレー量なら問題ありませんが、多く吹きかけた場合は清潔なタオルで拭き取ってください。
Q9.抗菌作用はありますか?
A.抗菌作用はありません。
人がよく触れるところは日常的に使用されるのをオススメします。
Q10.使ったらいけないところはありますか?
A.水を使ったらダメなところ以外は大丈夫です。
金属への影響はほとんどありませんが、水浸しになる状態で放置するのではなく拭き上げるようにしてください。
Q11.スプレーしたところを拭いたタオルはその都度洗濯が必要ですか?
A.その都度洗濯する必要はありませんが、1日の終わりには洗濯して乾燥までさせた方が衛生的です。
使用可能か確認できるテストペーパー「ヨウ化カリウムデンプン紙」

商品と一緒にテストペーパー「ヨウ化カリウムデンプン紙」もお届けしています。
お客様に効果的にご使用いただきたいからです。
テストペーパーは残留塩素濃度を確認でき、微酸性次亜塩素酸水(微酸性電解水)に効果があり使用可能かどうかを確かめるのに役立ちます。
使用可能な場合は、真っ白なペーパーに浸けたときに濃い青色に変化します。
ご使用になる前に効果を確かめるときや、使用期限が過ぎる頃の効果に不安を感じるときなどにご使用ください。
開発ストーリー
私たちの本業は清掃業です。
もうすぐ創業44年を迎えます。
以前は目に見える汚れをキレイにしていましたが、近年インフルエンザやノロウイルス、食中毒、口蹄疫等の被害が多発し、人はもちろん家畜にも被害が出るようになってきました。
私たちが住んでいる宮崎県では2010年に口蹄疫が流行してしまい、29万7,808頭もの家畜の命が奪われ、畜産業や地域経済、県民の生活は大きなダメージを受けました。
ウイルスや菌は目に見えないところに潜んでいます。
「私たちの技術でなんとかこれらの被害をなくしていこう!」
そういう想いで、次亜塩素酸水の仕入れ販売をスタートさせました。
2016年5月には、自社で微酸性次亜塩素酸水を製造できるように電解水生成装置を導入しました。
微酸性次亜塩素酸水は一般家庭をはじめ、介護施設、保育園、医療機関などでもご使用いただいき、インフルエンザが流行する時期でも「感染者を出さずに利用者の健康を保てている」といった嬉しい声も届いています。
しかし、2020年に起こったあることをきっかけに「次亜塩素酸ナトリウムは水で薄めれば次亜塩素酸水になる」と勘違いをされる方や、「次亜塩素酸水は危険だ」「除菌に効果はない、今すぐやめろ!」などといった風評被害を受けるようになってしまいました。
とても残念なことではありますが、こうなってしまったのは間違いを起こさないように、正しい使い方や次亜塩素酸水はどういったものなのかを理解してもらえるように伝えられていなかったことも関係していると思います。
そういうこともあり、私たちはお客様に安全性を理解してもらい、お客様を不安にさせないものを届けたい!という想いから、一般社団法人日本微酸性電解水協会に認可されている微酸性次亜塩素酸水(微酸性電解水)の生成装置を新たに導入し、使用の際の様々な負担を減らし、使用中に間違いが起こらないように安全な有効塩素濃度でのみお届けすることに決めました。
以前から環境や人に優しい洗剤を使用してきた私たちは、菌やウイルスを除菌・不活化でき、なおかつ人や環境にも優しい製品を扱えるようになりました。
そして、私たちはこの製品に「除菌ジアカインド」と名付けました。
「除菌ジアカインド」は強力な除菌力ですが、人や環境に優しいため「カインド(優しい)」という意味を持った名前にしました。
この商品で、インフルエンザやノロウイルス、食中毒、口蹄疫など人間家畜に害を及ぼす可能性のある菌やウイルスを除菌・不活化し、安心安全な生活をお届けするのが我社の使命と感じています。
皆様方のご健康が長く続くようにこの製品が役立つと幸いです。
私たちは、人や家畜に害のある菌やウイルスを除菌・不活化し、安心安全な生活環境の実現に貢献します。
長くなりましたが、私たちは本気でお客様の健康を守りたいと思っています。
あなたやあなたの大切な方々の健康を守るアイテムの1つとして、微酸性次亜塩素酸水「除菌ジアカインド」をあなたのそばに置いておいていただけると幸いです。
あなたの健康が守られ、安心と幸せを感じられる暮らしがずっと続くように祈っています。
お客様の声
いろんなシーンで大切な方々の健康を守るためにお役に立てて嬉しいです。
ありがとうございます!
◉ジアカインドが安心材料に!
近所で除菌スプレーも買えず、困っていて見つけました。
20リットルの除菌水は、とてもうれしく、何よりほっと安心できました。
実家の両親へ、友人へ、職場の同僚に、困っている人たちに配りました。
一緒に入っていたパンフレットもコピーして渡しました。とても喜ばれました。
洋服やバッグ、マスクの除菌が可能です。毎日たっぷり使っています。
ありがとうございました!
女性|50代(除菌ジアカインド20Lご購入)
◉助かりました!
医療関係の者です。
消毒用エタノールを使用していましたが、品薄になった今、微酸性次亜塩素酸水50ppm、ベストだと思います。
本当に助かりました。
ありがとうございます。
男性|60代(除菌ジアカインド20Lご購入)
◉商品説明が丁寧!!
商品説明が丁寧に書かれていて、分かりやすかったです。
商品の発送の知らせもあったので、いつ届くのかなぁっと心配も無かったです。
男性|40代(除菌ジアカインド1L×2パックご購入)
◉安心して使うことができました
感染症拡大の中、除菌できることが嬉しい。
消毒液や除菌液の中でも偽物が出回っていることから、このクリンシアさんはきちんとしたメーカーさんで安心して使うことができました。
女性|30代(除菌ジアカインド1L+250mlスプレー1本セットご購入)
-
レビュー
(0)
-
送料・配送方法について
-
お支払い方法について
¥1,485税込
¥1,980